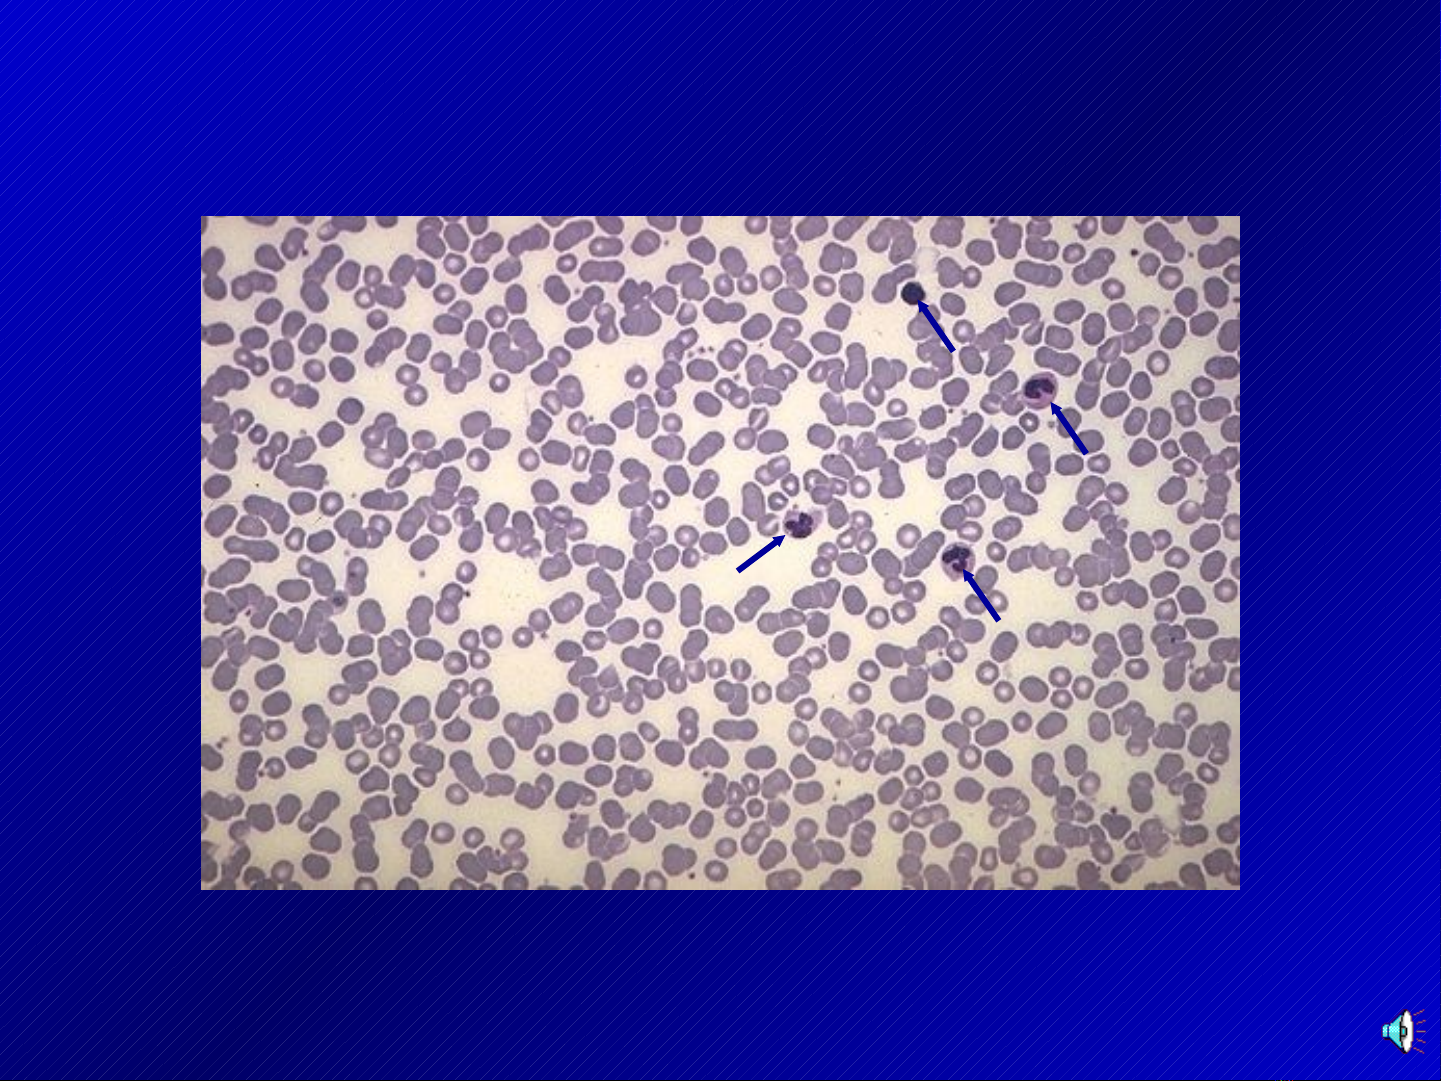

1

2
H å n g c Ç u
t i Ó u c Ç u
B c h ¹ t t r u n g t Ýn h
b c h ¹ t a a c i d
B C h ¹ t a b a s e
b ¹ c h c Ç u h ¹ t
b ¹ c h c Ç u ® ¬ n n h © n
l y m p h o b µ o n h á
l y m p h o b µ o t b
l y m p h o b µ o t o
l y m p h o b µ o ( T v µ B )
b ¹ c h c Ç u
t Õ b µ o m ¸ u
s î i h u y Õ t
h u y Õ t t h a n h
H u y Õ t t ¬ n g
m « m ¸ u
SƠ Đ C U T O MÔ MÁUỒ Ấ Ạ
3
TIÊU B N MÁU ẢĐÀN

4
H NG C UỒ Ầ

5
H NG C U VÀ TI U C U Ồ Ầ Ể Ầ
TRONG LÒNG M CHẠ

